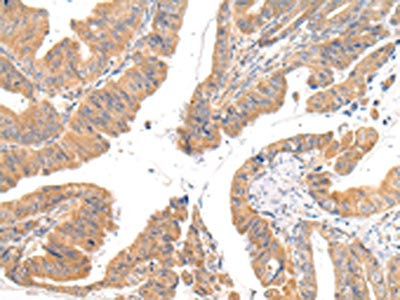

-
中文名稱:CMKLR1兔多克隆抗體
-
貨號:CSB-PA164672
-
規格:¥1100
-
圖片:
-
The image on the left is immunohistochemistry of paraffin-embedded Human thyroid cancer tissue using CSB-PA164672(CMKLR1 Antibody) at dilution 1/35, on the right is treated with synthetic peptide. (Original magnification: ×200)
-
The image on the left is immunohistochemistry of paraffin-embedded Human esophagus cancer tissue using CSB-PA164672(CMKLR1 Antibody) at dilution 1/35, on the right is treated with synthetic peptide. (Original magnification: ×200)
-
-
其他:
產品詳情
-
Uniprot No.:
-
基因名:
-
別名:CMKLR1; CHEMR23; DEZ; Chemerin-like receptor 1; Chemokine-like receptor 1; G-protein coupled receptor ChemR23; G-protein coupled receptor DEZ
-
宿主:Rabbit
-
反應種屬:Human
-
免疫原:Synthetic peptide of Human CMKLR1
-
免疫原種屬:Homo sapiens (Human)
-
標記方式:Non-conjugated
-
抗體亞型:IgG
-
純化方式:Antigen affinity purification
-
濃度:It differs from different batches. Please contact us to confirm it.
-
保存緩沖液:-20°C, pH7.4 PBS, 0.05% NaN3, 40% Glycerol
-
產品提供形式:Liquid
-
應用范圍:ELISA,IHC
-
推薦稀釋比:
Application Recommended Dilution ELISA 1:2000-1:5000 IHC 1:25-1:100 -
Protocols:
-
儲存條件:Upon receipt, store at -20°C or -80°C. Avoid repeated freeze.
-
貨期:Basically, we can dispatch the products out in 1-3 working days after receiving your orders. Delivery time maybe differs from different purchasing way or location, please kindly consult your local distributors for specific delivery time.
-
用途:For Research Use Only. Not for use in diagnostic or therapeutic procedures.
相關產品
靶點詳情
-
功能:Receptor for the chemoattractant adipokine chemerin/RARRES2 and for the omega-3 fatty acid derived molecule resolvin E1. Interaction with RARRES2 initiates activation of G proteins G(i)/G(o) and beta-arrestin pathways inducing cellular responses via second messenger pathways such as intracellular calcium mobilization, phosphorylation of MAP kinases MAPK1/MAPK3 (ERK1/2), TYRO3, MAPK14/P38MAPK and PI3K leading to multifunctional effects, like, reduction of immune responses, enhancing of adipogenesis and angionesis PubMed:27716822. Resolvin E1 down-regulates cytokine production in macrophages by reducing the activation of MAPK1/3 (ERK1/2) and NF-kappa-B. Positively regulates adipogenesis and adipocyte metabolism.; (Microbial infection) Acts as a coreceptor for several SIV strains (SIVMAC316, SIVMAC239, SIVMACL7E-FR and SIVSM62A), as well as a primary HIV-1 strain (92UG024-2).
-
基因功能參考文獻:
- levels in cord blood, peripheral blood, adipose tissue and placenta tissue significantly higher in gestational diabetes PMID: 29430984
- CMKLR1 and GPR1 were widely expressed in vascular smooth muscle. PMID: 27742615
- Both ALX and ChemR23 were present in human synovium and medial tibial plateau bone obtained following total knee replacement surgery for osteoarthritis. PMID: 27860453
- Results show that ChemR23 is highly expressed in squamous oesophageal cancer tumors and cell lines. PMID: 27092781
- CMKLR1 exacerbated the proliferation and migration of VSMCs by activating ERK1/2. PMID: 27792688
- We demonstrated that chemerin is linked to metabolic syndrome components. Moreover, serum chemerin levels were associated significantly with obesity, especially visceral adipose tissue, in subjects with T2DM [type 2 diabetes mellitus]. PMID: 28120562
- Study shows that hepatic CMKLR1 mRNA is weakly associated with features of NASH in male patients only. PMID: 27548138
- Our results show that higher levels of circulating chemerin, CRP, fibrinogen, and ESR are associated with an increased risk of developing colorectal cancer PMID: 26628300
- Data show inverse Relationship of the CMKLR1 Relative Expression and Chemerin Serum Levels in Obesity with Dysmetabolic Phenotype and Insulin Resistance PMID: 27239101
- Results indicate that Abeta42 activates CMKLR1, leading to glia cell migration and clearance of Abeta42; and is involved in Abeta processing and clearance PMID: 25079809
- Gestational obesity and gestational diabetes mellitus may contribute to elevated serum chemerin. Serum chemerin in pregnancy was associated with insulin resistance and triglycerides. Chemerin gene may play a role both in obese and gestational diabetes mellitus patients PMID: 25627894
- Increased chemerin expression in dermal blood vessels may be associated with the development of digital ulcers in systemic sclerosis. PMID: 25539827
- The study for the first time confirmed a marked expression of chemerin and CMKLR1 in the liver of chronic hepatitis patients. PMID: 25121101
- ChemR23, the receptor for chemerin and resolvin E1, is expressed and functional on M1 but not on M2 macrophages. PMID: 25637017
- The effects of diclofenac on the incidence of pancreatitis following endoscopic retrograde cholangiopancreatography via lipoxin A4 and resolvin D1 and E1 levels is reported. PMID: 25030943
- Results lend some support to a presumable role of locally produced chemerin in the progression of atherosclerotic lesions, possibly acting through its CMKLR1 receptor. PMID: 24779513
- This study identified the up-regulation of ChemR23 in post-traumatic injury of calcaneal articular fracture PMID: 24689495
- ChemR23 is expressed in neutrophil granules and rapidly upregulated upon neutrophil activation. PMID: 23999103
- Development of a membrane-anchored chemerin receptor agonist as a novel modulator of allergic airway inflammation and neuropathic pain. PMID: 24659779
- Chemerin receptor showed increased expression in the lymph nodes and the spleen. PMID: 23904282
- Prochemerin processing protease converts prochemerin into active chemerinF; the activating truncation by the protease may trigger a structural C-terminal rearrangement leading to increased affinity of chemerin to chemokine-like receptor (CMKLR)1. PMID: 23495698
- review of current research on biological roles of chemerin and chemokine-like receptor 1; highlight roles in mediating obesity and development of type 2 diabetes [REVIEW] PMID: 22610747
- The interaction of chemerin and ChemR23 may play an important role in the pathogenesis of rheumatoid arthritis through the resultant activation of fibroblast-like synoviocytes. PMID: 21959042
- These results rule out the direct anti-inflammatory effect of chemerin on macrophages ex vivo, described previously in the literature, despite the expression of a functional ChemR23 receptor in these cells. PMID: 22768214
- Chemerin, a ligand for the G-protein coupled receptor chemokine-like receptor 1, requires carboxy-terminal proteolytic processing to unleash its chemoattractant activity PMID: 21715684
- The ChemR23/Chemerin axis may have a role in the recruitment of dendritic cells within the kidney in patients affected by lupus nephritis. PMID: 21346723
- A genetic variation in the chemokine-like receptor 1 (CMKLR1) gene was statistically significantly associated with decreased overall survival in the three individual populations as well as in pooled analyses. PMID: 21483023
- These results demonstrate that human chondrocytes express both the receptor ChemR23 and the ligand chemerin...which may play pivotal roles in joint inflammation. PMID: 21192818
- the presence of ChemR23 in human endothelial cells, its significant up-regulation by pro-inflammatory cytokines, and its role in angiogenesis were demonstrated. PMID: 20044979
- RvE1 initiates direct activation of ChemR23 and signals receptor-dependent phosphorylation PMID: 19906641
- ChemR23 mediates the Resolvin E1 signal to attenuate nuclear factor-kappaB PMID: 15753205
- The results strongly support that the chemerin receptor, in the presence of CD4, functions as a "minor co-receptor" promoting infection by HIV-1, HIV-2 and SIV. PMID: 16904155
- CMKLR1 is expressed by circulating pDC in normal individuals and patients suffering from skin diseases, such as psoriasis and atopic dermatitis. PMID: 19168032
顯示更多
收起更多
-
亞細胞定位:Cell membrane; Multi-pass membrane protein.
-
蛋白家族:G-protein coupled receptor 1 family
-
組織特異性:Prominently expressed in developing osseous and cartilaginous tissue. Also found in adult parathyroid glands. Expressed in cardiovascular system, brain, kidney, gastrointestinal tissues and myeloid tissues. Expressed in a broad array of tissues associated
-
數據庫鏈接:
Most popular with customers
-
-
YWHAB Recombinant Monoclonal Antibody
Applications: ELISA, WB, IHC, IF, FC
Species Reactivity: Human, Mouse, Rat
-
Phospho-YAP1 (S127) Recombinant Monoclonal Antibody
Applications: ELISA, WB, IHC
Species Reactivity: Human
-
-
-
-
-